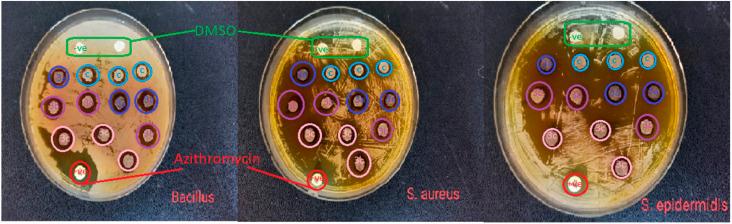

含噻唑部分的偶氮-噻唑衍生物的协同研究:对其合成、表征、计算分析、溶剂化显色以及多模式生物活性评估的全面探索
A synergistic investigation of azo-thiazole derivatives incorporating thiazole moieties: a comprehensive exploration of their synthesis, characterization, computational insights, solvatochromism, and multimodal biological activity assessment.
作者信息
Muhammed Aziz Dara, Hassan Sangar Ali, Amin Alla Ahmad M, Abdullah Media Noori, Qurbani Karzan, Aziz Shujahadeen B
机构信息
Department of Chemistry, College of Sciences, University of Raparin, Kurdistan Regional Government Main Street Ranyah 46012 Iraq
Department of Chemistry, College of Science, Salahaddin University Erbil 44002 Iraq.
出版信息
RSC Adv. 2023 Nov 24;13(49):34534-34555. doi: 10.1039/d3ra06469g. eCollection 2023 Nov 22.
In the present study, a novel series of azo-thiazole derivatives (3a-c) containing a thiazole moiety was successfully synthesized. The structure of these derivatives was examined by spectroscopic techniques, including H NMR, C NMR, FT-IR, and HRMS. Further, the novel synthesized compounds were evaluated for their biological activities, such as antibacterial and anti-inflammatory activities, and an study was performed. The antibacterial results demonstrated that compounds 3a and 3c (MIC = 10 μg mL) have a notable potency against compared to azithromycin (MIC = 40 μg mL). Alternatively, compound 3b displayed a four-fold higher potency (24 recovery days, 1.83 mg day) than Hamazine (28 recovery days, 4.14 mg day) in promoting burn wound healing, and it also exhibited a comparable inhibitory activity against screened bacterial pathogens compared to the reference drug. Docking on 1KZN, considering the excellent impact of compounds on the crystal structure of 1KZN, a 24 kDa domain, in complex with clorobiocin, indicated the close binding of compounds 3a-c with the active site of the 1KZN protein, which is consistent with their observed biological activity. Additionally, we conducted molecular dynamics simulations on the docked complexes of compounds 3a-c with 1KZN retrieved from the PDB to assess their stability and molecular interactions. Furthermore, we assessed their electrochemical characteristics DFT calculations. Employing PASS and pkCSM platforms, we gained insights into controlling the bioactivity and physicochemical features of these compounds, highlighting their potential as new active agents.
在本研究中,成功合成了一系列含有噻唑部分的新型偶氮 - 噻唑衍生物(3a - c)。通过光谱技术对这些衍生物的结构进行了检测,包括氢核磁共振(H NMR)、碳核磁共振(C NMR)、傅里叶变换红外光谱(FT - IR)和高分辨率质谱(HRMS)。此外,对新合成的化合物进行了生物活性评估,如抗菌和抗炎活性,并开展了一项研究。抗菌结果表明,与阿奇霉素(最低抑菌浓度 = 40 μg/mL)相比,化合物3a和3c(最低抑菌浓度 = 10 μg/mL)具有显著的抗菌效力。另外,在促进烧伤创面愈合方面,化合物3b的效力比哈马嗪(28天愈合,4.14 mg/天)高四倍(24天愈合,1.83 mg/天),并且与参考药物相比,它对筛选出的细菌病原体也表现出相当的抑制活性。基于1KZN进行对接,考虑到化合物对与氯法齐明复合的1KZN的24 kDa结构域晶体结构的优异影响,表明化合物3a - c与1KZN蛋白的活性位点紧密结合,这与其观察到的生物活性一致。此外,我们对从蛋白质数据银行(PDB)检索到的化合物3a - c与1KZN的对接复合物进行了分子动力学模拟,以评估它们的稳定性和分子相互作用。此外,我们通过密度泛函理论(DFT)计算评估了它们的电化学特性。利用PASS和pkCSM平台,我们深入了解了如何控制这些化合物的生物活性和物理化学特性,突出了它们作为新型活性剂的潜力。